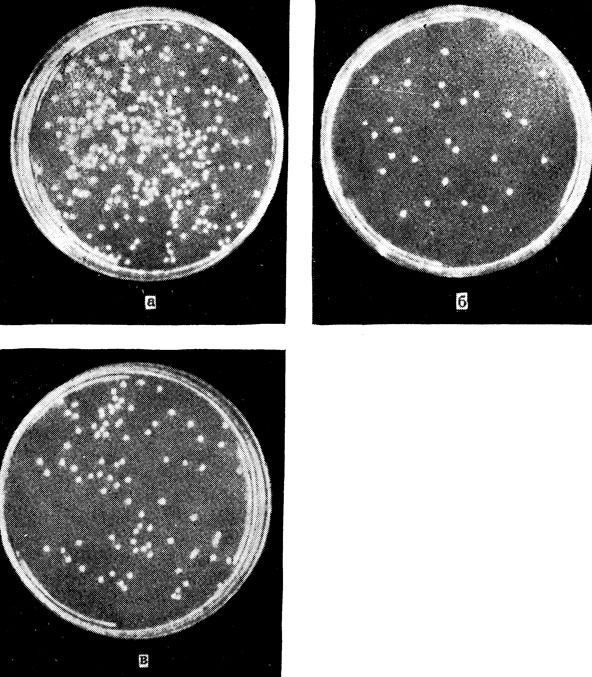

Восстанавливаются ли лучевые повреждения?
Еще совсем недавно - в 40 - 50-х годах нашего столетия, ученые были убеждены, что повреждения, нанесенные живым клеткам ядерными излучениями, мгновенны и необратимы, что они являются следствием попадания ионизирующего кванта или частицы в "мишень" - наиболее уязвимую и чувствительную часть клетки, которую обычно отождествляли с ее ядром или хромосомами. Согласно этой теории, попадание в мишень означало неотвратимую гибель клетки. Чем больше доза радиации, тем больше количество поврежденных клеток, тем сильнее страдает функция органа и всего организма. Восстановление пострадавшего органа и организма относили за счет усиленного размножения уцелевших от поражения клеток.
Однако вскоре появились первые доказательства того, что в действительности дело не столь безнадежно, что пораженная радиацией клетка сохраняет запас жизненных сил и при определенных условиях способна полностью ликвидировать нанесенный ей смертельный урон.
Назовем имена исследователей, открывших новую главу в книге знаний о действии ядерных излучений на живые клетки. Это американцы Альпер и Кимболл, советские исследователи В. И. Корогодин, Н. В. Лучник и Л. С. Царапкин. Работы этих ученых не опровергли полностью теорию "мишени": ведь в клетке действительно существуют участки более или менее важные, более или менее чувствительные к действию радиации. Новое заключалось в доказательстве того, что попадание ионизирующей частицы в мишень-наиболее чувствительный и ответственный участок клетки - еще не означает автоматической ее гибели.
Чтобы познакомиться с деятельностью механизмов восстановления клетки, следует прежде всего разобраться в вопросе, какие именно структуры клетки соответствуют понятию "мишень", повреждение чего ведет обычно к гибели клетки. Уже давно ученые пришли к выводу, что мишень локализуется в ядре. Ионизирующая частица, пролетая, вызывает в ядре и в цитоплазме одинаковые в физическом смысле изменения. Особая чувствительность мишени связана, очевидно, с тем, что ее функция необходима для нормальной жизнедеятельности клетки, а повреждение вызывает глубокие, несовместимые с жизнью изменения.
Итак, мишень - жизненно важные, единственные в своем роде, уникальные внутриклеточные структуры. Очевидно, под это понятие больше всего подходят хромосомы, в особенности важнейшая их составная часть - молекулы ДНК, каждая из которых несет свой особый, уникальный набор генов, необходимых для синтеза клеточных белков. Значит, основная проблема восстановления пораженной радиацией клетки - восстановление поврежденной ДНК. Все остальные компоненты клетки, даже ферментные белки, содержатся в клетке в виде более или менее значительного количества дубликатов. Разрушение нескольких из них еще не фатально. Кроме того, при целости исходного штампа, матрицы - ДНК - клетка всегда имеет возможность отштамповать нужное количество копий.
Поврежденный же участок молекулы ДНК (ген) может способствовать производству измененного белка вместо нормального либо вообще окажется непригодным для синтеза белка. Само по себе это еще не очень опасно: имевшихся в клетке до облучения молекул фермента может быть достаточно для жизнедеятельности. Но вот в жизни клетки наступает момент, когда выявляются, становятся очевидными все дотоле скрытые повреждения генетического аппарата. Это деление клетки, митоз. Его необходимой предпосылкой является самоудвоение ДНК, призванное обеспечить каждую из дочерних клеток полным комплектом наследственной информации. Начинается процесс с расхождения нитей ДНК, на каждой из которых синтезируется новая. Попадание ионизирующей частицы могло привести к разрыву обеих нитей ДНК; тогда молекула оказывается разделенной на два отломка. В процессе митоза один или оба отломка могут потеряться либо неправильно соединиться. Если в результате попадания образуется прочная поперечная связь между нитями ДНК, они не смогут разойтись и приступить к самоудвоению. Разрыв одной нити ДНК не удается выявить до наступления митоза никакими методами. Зато после расхождения нитей ДНК дефект сразу становится явным и может привести к гибели дочерней клетки или ее потомков.
Существуют и другие виды повреждений ДНК ядерными излучениями. Во всех этих случаях клетка гибнет, так как митоз не может осуществиться либо он приводит к образованию неполноценных клеток, гибнущих при попытке разделиться. Митоз, таким образом, оказывается переломным периодом в жизни клетки, своеобразным строгим экзаменом на жизнеспособность и полноценность.
Может ли клетка самостоятельно, без помощи и вмешательства извне устранить образовавшийся дефект? Как доказать наличие в клетке такого восстановительного механизма?
Ученые долго работали над этой проблемой, а решение, как часто бывает, оказалось простым. Дефекты ДНК, как мы уже знаем, отчетливо обнаруживаются в момент вступления клетки в митоз. А что, если увеличить промежуток времени между моментом воздействия излучения и митозом? Если никакого внутриклеточного восстановления не происходит, задержка митоза не повлияет на количество поврежденных клеток в ткани или в культуре вне организма. Если же восстановление имеет место, то отсрочка митоза облегчит ремонтные работы и увеличит количество восстановленных клеток; размер повреждения достоверно уменьшится.
Такого рода эксперименты были поставлены. Известно много способов искусственной задержки митоза. Если суспензию бактерий, дрожжей, культуру клеток млекопитающих перенести в среду, содержащую мало питательных веществ или лишенную некоторых витаминов, клетки в таких условиях не делятся или делятся с большим опозданием. Если суспензию дрожжей сразу после облучения дозой радиации, вызывающей гибель 50% клеток, разделить надвое и поместить одну половину в обычную питательную жидкость, а вторую - в водопроводную воду, то уже через сутки можно получить ответ на интересующий нас вопрос. Дрожжи, попавшие в жидкую питательную среду, начинают интенсивно почковаться. Если через несколько часов высеять их на твердую питательную среду, то каждая живая неповрежденная клетка образует за сутки микроколонию из нескольких сотен и даже тысяч клеток, хорошо видную под микроскопом. А поврежденные радиацией клетки либо совсем не делятся, либо образуют нити или микроколонии из нескольких клеток.
Дрожжи, выдержанные несколько часов в водопроводной воде и затем высеянные на твердую среду, образуют, как показал опыт, вдвое больше микроколоний, чем содержавшиеся после облучения в питательной жидкости, и почти столько же, сколько образуют в этих же условиях необлученные дрожжи.
Выходит, такое простое мероприятие, как искусственная задержка митозов на несколько часов, способствует почти полному устранению вреда, нанесенного большой дозой ядерных излучений. Значит, восстановительная система клетки существует, и задержка митоза облегчает ее функционирование, повышает эффективность.
Рис. 4. Фотореактивация. а - контроль: чашка содержит 368 колоний кишечной палочки, б - после воздействия ультрафиолетовыми лучами выжило и образовало колонии 36 бактерий, в - после ультрафиолетового облучения и освещения видимым светом количество колоний возросло до 93
Существуют различные объяснения этого интереснейшего факта. Если повреждение ДНК в большой мере вызвано действием образующихся внутри клетки радиотоксинов, то выдерживание клеток в водопроводной воде облегчает удаление ядовитых веществ. После облучения проницаемость клеточных оболочек увеличивается. И не исключено, что сдвиг проницаемости способствует восстановлению, облегчая и увеличивая отток из клетки радиотоксинов.
Но есть и другие предположения. Наиболее распространенная точка зрения состоит в том, что ядерные излучения повреждают молекулы ДНК в результате прямого попадания ионизирующей частицы или косвенно, через посредство водных радикалов или радиотоксинов. Но эти повреждения еще не носят необратимого характера, это, так сказать, потенциальные повреждения. Если внутриклеточная восстановительная система не успевает устранить повреждения в ДНК до начала деления, они в ходе митоза реализуются, становятся необратимыми.
Прошло еще несколько лет, и ученые получили первые данные о том, что же собой представляет восстановительная система клетки, как она работает. Этому помогли открытия в смежной области - защиты от ультрафиолетовых лучей.
Началось с того, что в 1949 г. двое ученых, даже не подозревавших о существовании друг друга: И. Ф. Ковалев в СССР, в Одесском институте глазных болезней им. В. П. Филатова, и А. Кельнер в США, в институте Карнеги, одновременно открыли новое явление, которое затем получило в науке название фотореактивации. Микроорганизмы, облученные большой дозой ультрафиолетовых лучей (И. Ф. Ковалев работал с инфузориями, а А. Кельнер - с кишечной палочкой и грибками актиномицетами), в темноте быстро погибали; на рассеянном солнечном свету или при специальном освещении (лампой дневного света, накаливания или ртутной), выживало уже 20 - 50% облученных микроорганизмов, а иногда даже до 70-80%. Очевидно, видимый свет способствует "выздоровлению" облученных клеток, ускоряет восстановление нанесенных им повреждений (рис. 4).
Вскоре удалось установить, что повреждающее действие ультрафиолетовых лучей прежде всего сказывается на нуклеиновых кислотах клетки. Ультрафиолетовые лучи с длиной волны 2500 - 2700 А, легко поглощаемые нуклеиновыми кислотами, обладают наибольшим бактерицидным действием.
Механизм поражающего действия ультрафиолетовых лучей и фотореактивации был более глубоко изучен и понят лишь после того, как удалось раскрыть структуру молекул ДНК и их роль в процессах жизнедеятельности клеток. Оказалось, что бактерицидное действие ультрафиолетовых лучей главным образом объясняется образованием в ДНК одного специфического дефекта. Энергия ультрафиолетовых лучей, поглощенных азотистыми основаниями ДНК, особенно тимином, расходуется на разрыв двойной связи в тиминовом кольце. Если одновременно разрываются связи в двух близко расположенных кольцах тимина, то между ними образуется двойная связь. Образование таких соединений- димеров тимина - облегчает спиральная структура молекулы ДНК.
Димеры тимина препятствуют удвоению молекулы ДНК Примерно так же, как два слившихся зубца в застежке-молнии мешают ее раскрытию. Клетки, в которых образовалось несколько таких дефектов, теряют способность делиться и гибнут. Образование димеров тимина - главная причина бактерицидного действия ультрафиолетовых лучей. Поэтому бактерии, у которых ДНК богата тимином, особенно чувствительны к ультрафиолетовой инактивации.
Каким же образом видимый свет, действующий после ультрафиолета (эффект воспроизводится в интервале трех часов) может устранять возникшие дефекты? Чисто физические механизмы оказались непригодными для объяснения. А само явление фотореактивации вызвало очень большой интерес у ученых, когда выяснилось, что оно наблюдается не только у бактерий и грибков, но и у простейших (инфузорий, кольпидий, амеб), иглокожих (морских ежей), водорослей, низших и высших растений, земноводных и млекопитающих.
Первое представление о работе этого механизма ученые получили тогда, когда удалось при длительном облучении разновидности кишечной палочки, особенно устойчивой к радиации, получить форму, отличающуюся очень высокой радиочувствительностью. Измененный микроорганизм во всех остальных отношениях не отличался от устойчивого штамма, но погибал при дозах радиации, не влияющих на здоровье исходной разновидности. Высокая чувствительность нового штамма связана, вероятно, с нарушением функции восстановительной системы. Поскольку возникшие изменения - результат нарушения продукции одного или нескольких ферментов, можно предположить, что и темновая реактивация, подобно фотореактивации, осуществляется одним или несколькими ферментами. Сейчас ученые выделяют эти ферменты и изучают их свойства; кое-что о механизме "починки" поврежденной ДНК мы уже знаем.
Если фермент фотореактивации попросту расщепляет димеры тимина, то ферменты темнового восстановления, имеющие дело с более грубыми и разнообразными повреждениями ДНК, действуют иначе (рис. 5). Сначала поврежденный участок молекулы ДНК (одной ее цепочки) удаляется вместе с соседними неповрежденными нуклеотидами; благодаря второй цепочке целостность молекулы при этом не нарушается. Затем к месту дефекта поступают строительные материалы: азотистые основания, фосфаты, сахара, и целостность "оперированной" нити ДНК восстанавливается. Азотистые основания на отремонтированном участке выстраиваются не как придется, а в том же порядке, в каком были в нити ДНК до облучения. Это достигается благодаря присутствию второй, комплементарной нити, каждое азотистое соединение которой подбирает себе строго определенную пару. Восстанавливается, таким образом, не только целостность структуры молекулы ДНК, но и полный объем наследственной информации, закодированной в ней. Каждый этап темновой репарации (удаление повреждения, расширение дефекта, синтез нового участка цепи, сшивание нити) осуществляется при участии отдельного фермента или ферментной системы.
Чтобы установить все детали этого процесса, ученым Р. Сэтлоу и П. Говард-Фландерсу пришлось осуществить очень тонкие опыты на культурах облученных микробов, размножающихся в среде с тимином, содержащим метку, - радиоактивный атом трития Н3 (тяжелого изотопа водорода). Им удалось показать, что у бактерий, чувствительных к облучению, вся метка оказалась включенной в ДНК, тогда как у устойчивой к радиации культуры микробов часть метки содержалась в небольших фрагментах ДНК, очевидно, удаленных из молекулы в процессе ее ремонта. В других исследованиях в качестве метки был использован искусственный аналог тимина - 5-бромурацил.
ДНК, отремонтированная группой ферментов темновой реактивации, способна, как показали специальные исследования, к удвоению и к передаче наследственной информации, что является гарантией высокого качества проведенного ремонта.
Итак, микроорганизмы и клетки более сложно устроенных живых существ обладают очень точным и быстродействующим ферментативным механизмом, осуществляющим "текущий ремонт" молекул ДНК, исправление возникающих в них лучевых дефектов - защиту ДНК от разрушительного действия излучений.

Рис. 5. Схема процесса темнового восстановления структуры ДНК, поврежденной радиацией а - двойная цепочка ДНК с дефектом (димер темина), б - разрыв дефектной цепи, в - удаление поврежденного участка нити ДНК, г - восстановление исходной структуры ДНК
Но не только излучения нарушают структуру ДНК, искажая смысл кодированных сообщений. Большая группа химических веществ, не только созданных руками человека, но и возникающих внутри организма в ходе процессов обмена веществ, взаимодействуя с азотистыми основаниями или другими компонентами ДНК, вносит ошибки в наследственный код. Такими свойствами обладают, в частности, хиноидные и липидные радиотоксины и другие необычные вещества, накапливающиеся в облученном организме. Очевидно, и многие повреждения ДНК, вызываемые химическими препаратами, устраняются в процессе восстановления. Очень интересно и важно было бы установить, существуют ли специальные ферментные механизмы для противодействия каждому из вредоносных агентов, или все эти повреждения устраняются одной восстановительной системой.
Чтобы ответить на этот вопрос, ученым также пришлось проделать огромную работу: изучить закономерности действия на ДНК различных физических и химических агентов, особенности восстановления в каждом случае, затем сопоставить их между собой. Лишь после этого был получен важный вывод: наряду со специфическим механизмом фотореактивации существует общий механизм исправления дефектов структуры ДНК самой разнообразной природы. Ферменты, осуществляющие процесс темновой реактивации, "распознают" не отдельные измененные или поврежденные азотистые основания, а те деформации и нарушения, которые эти дефекты вносят в спирально-осевую структуру молекулы ДНК в целом. Дефектный участок ДНК устраняется и заменяется аналогичным по структуре нормальным участком, независимо от причины и характера дефекта.
Очевидно, присутствие в клетках описанной восстановительной системы имеет значение не только в плане нейтрализации отдельных вредных воздействий. Роль этого механизма значительно шире и важнее: защита от разнообразных повреждений и воздействий такого вещества, как ДНК, выполняющего роль хранителя и передатчика наследственной информации, способствует сохранению постоянства признаков организмов и видов, обеспечивает повторение, воспроизведение в длинном ряду поколений прародительских свойств, одним словом, гарантирует постоянство наследственных задатков.
Свыше 100 лет тому назад немецкий ученый Август Вейсман попытался экспериментально разрешить вопрос, могут ли передаваться по наследству признаки, приобретенные на протяжении жизни отдельного организма. Несколько сот поколений лабораторных мышей прошло через его руки. Каждой из них до скрещивания ученый аккуратно отрезал хвост, а затем измерял длину хвоста у потомков. Несмотря на столь длительное повторное воздействие, длина хвоста у новорожденных не уменьшалась ни на миллиметр. Из своих опытов Вейсман сделал вывод, который в наши дни, на фоне успехов генетики, молекулярной биологии и других наук, звучит весьма странно и даже анекдотически: приобретаемые организмом свойства не наследуются, поскольку наследственное вещество, ответственное за передачу признаков организма, бессмертно и независимо от подверженного влияниям смертного тела.
И все же, при всей странности выводов Вейсмана, с современной точки зрения, в них содержалось важное рациональное зерно: большинство признаков, приобретенных организмом в процессе жизнедеятельности, действительно не передается потомкам. Простой житейский опыт убеждает, что дети молотобойца или грузчика не наследуют его мощной мускулатуры, так же как дети инвалида войны лишены его увечий. Постоянство видовых и индивидуальных признаков в длинном ряду поколений обеспечивается существованием сложного и стройного механизма кодирования, сохранения, воспроизведения и передачи наследственной информации, особенностями устройства и обмена ДНК (которая, в отличие от белков, неохотно вступает в большинство биохимических реакций). Теперь мы знаем, что в обеспечении постоянства наследственных задатков организмов, в защите их от влияний среды немаловажная роль принадлежит и общему механизму восстановления повреждений ДНК, механизму исправления ошибок генетического кода.
Но ведь постоянство видовых свойств все-таки относительно: время от времени среди массы особей данного вида возникают новые признаки, виды изменяются, появляются новые, весь органический мир развивается, эволюционирует - это хорошо известно со времен Дарвина. Значит, какая-то часть повреждений ДНК все-таки остается неустраненной, и за счет этих изменений - мутаций, появляются новые признаки и свойства; наряду с наследственностью существует и изменчивость организмов. Из массы возникающих изменений механизм отбора, естественного или искусственного, сохраняет наиболее ценные, полезные признаки, способствующие эволюции вида, его лучшему приспособлению к условиям среды.
Следовательно, для успешного развития вида, его эволюции и выживания необходимо оптимальное соотношение между наследственностью и изменчивостью, оптимальная частота возникающих новых признаков. Вид, создавший в ходе эволюции слишком совершенную систему устранения дефектов ДНК, становится консервативным, не поспевает в своем развитии за изменением среды и в конечном счете перестает эволюционировать, оказывается в тупике и даже может погибнуть.
Существование системы исправления повреждений ДНК имеет не только общебиологическое, эволюционное значение. Важна роль этой системы в регуляции устойчивости организма, отдельных его клеток и тканей к радиации. Познав в деталях механизм исправления дефектов, люди смогут управлять им, по желанию повышая сопротивляемость важных органов действию радиации или искусственно повышая чувствительность опухолевой ткани к лучевой терапии.
От каких же факторов зависит эффективность деятельности восстановительной системы? Некоторые из этих факторов нам уже известны. Прежде всего это частота митозов: если она достаточно высока, интервал между облучением и митозом по крайней мере частично обеспечивает возможность восстановления. Снижение частоты митозов, достигаемое любым возможным методом (гипотермия, гипоксия, введение антимитотических средств типа колхицина, уретана, адреналина и т. п.), дает более или менее значительный противолучевой эффект главным образом благодаря деятельности восстановительной системы.
Реакция торможения митозов является у высокоорганизованных живых существ стереотипным, неспецифическим ответом на самые разнообразные воздействия. Шум, яркий свет, электрические и механические раздражения, колебания температуры и действие других физических и химических агентов более или менее значительной интенсивности - все они вызывают кратковременную, но ясно выраженную реакцию торможения митозов.
Можно полагать, что эта реакция имеет двоякое значение для жизнедеятельности организма. С одной стороны, она как бы сосредоточивает клетки на выполнении их специфической деятельности, в той или иной степени необходимой для правильного ответа на действующий раздражитель; не отвлекаясь для митотического деления, клетки, ткани и органы, очевидно, функционируют более полноценно. С другой стороны, реакция торможения митозов как бы заблаговременно мобилизует организм на борьбу с возможной опасностью, переводит его в состояние максимальной устойчивости и сопротивляемости, причем важнейшее значение имеет создание оптимальных условий для деятельности восстановительной системы.
Помимо частоты митозов эффективность работы восстановительного механизма ограничивается еще и размером повреждения. Если в молекуле ДНК одновременно разрываются обе нити, то такой разрыв чаще всего уже не восстанавливается: отсутствует образец, по которому ферменты темновой реактивации осуществляют ресинтез поврежденной полинуклеотидной цепи. Виды излучений, отличающиеся большей величиной линейных потерь энергии, большей плотностью ионизации (нейтроны, протоны, альфа-частицы и более тяжелые многозарядные ядра), вызывают в клетках более грубые повреждения, чаще обусловливают появление двойных разрывов в молекулах ДНК, которые почти не восстанавливаются. В этом одна из причин высокой биологической эффективности подобных излучений, их опасности для живых клеток и организмов.
Итак, лучевое поражение - не мгновенный необратимый процесс, фатально определяющий судьбу облученной клетки в самый момент воздействия. Доказано, что в облученной клетке протекают сложнейшие процессы, усиливающие и ослабляющие тяжесть поражения, борются противоположные силы и влияния. Деятельность общего механизма исправления ошибок, ферментной восстановительной системы в значительной степени определяет исход борьбы, склоняя чашу весов в сторону сохранения жизнеспособности, выживания облученной клетки. Познав детали механизма восстановления, люди научатся управлять им, усиливать защиту от радиации жизненно важных органов, а в ткани опухоли искусственно повышать чувствительность к лучевому лечению. Власть над одним из важнейших механизмов живого позволит использовать его и для разработки более эффективных и быстрых способов выведения новых сортов культурных растений и пород животных, направленного изменения наследственности организмов и лечения наследственных болезней. Так сугубо научные и, казалось бы, далекие от жизни исследования рано или поздно начинают непосредственно служить людям, приносить конкретную пользу.
Более 800 000 книг и аудиокниг! 📚
Получи 2 месяца Литрес Подписки в подарок и наслаждайся неограниченным чтением
ПОЛУЧИТЬ ПОДАРОК